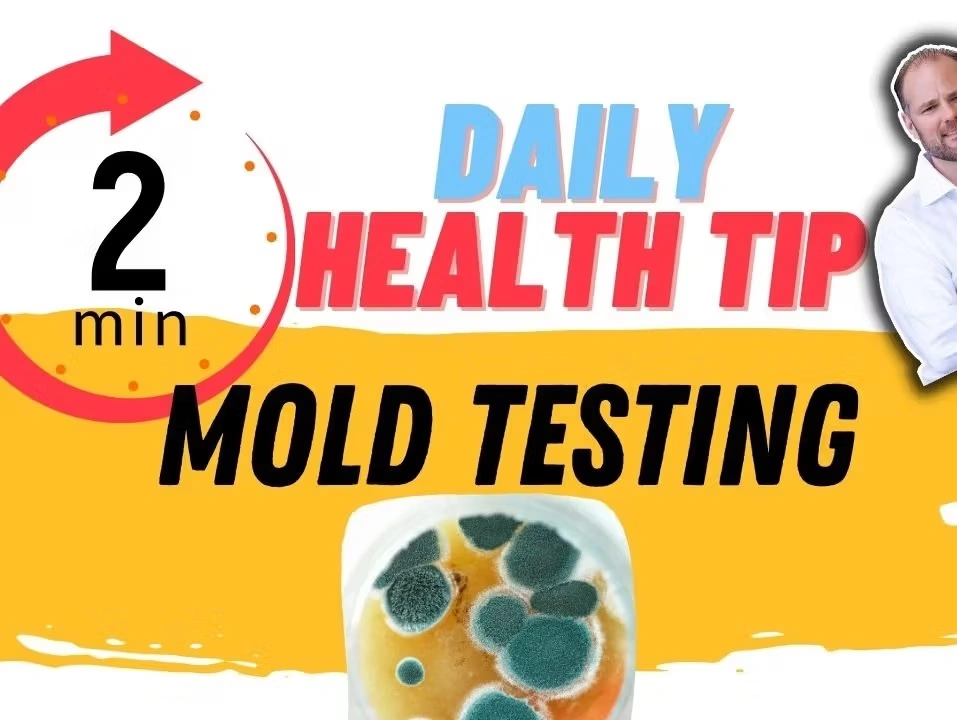
Graphic for a daily health tip about mold testing for chronic health conditions, showing a petri dish with mold.

Mold of 5700 to ZERO in 9 months | See 4 follow up tests!

Mold exposure and chronic mold infection can cause huge problems for the body including depression, fatigue, digestive issues, and infection
Putting the Brakes on Neuropathy and Mold

Learn how fish oil supports myelin repair, reduces inflammation, and may help manage neurological conditions and chronic pain. Ensure proper dosage and quality for best results.
Mold Exposure and Its Impact on Gut Health

Learn how hidden mold exposure can impact your health and why proper testing for mold toxicity is essential for accurate diagnosis and recovery.
Mold Side Effects: Unveiling the Hidden Culprit Behind Chronic Conditions

Explore the serious side effects of mold exposure through real patient experiences and understand how it can impact your health and recovery journey.
Mold testing explained in one-minute!
Living with a chronic health condition? Mold could be the hidden cause. Affordable at-home testing is available—schedule a call with Dr. Hugh today!
